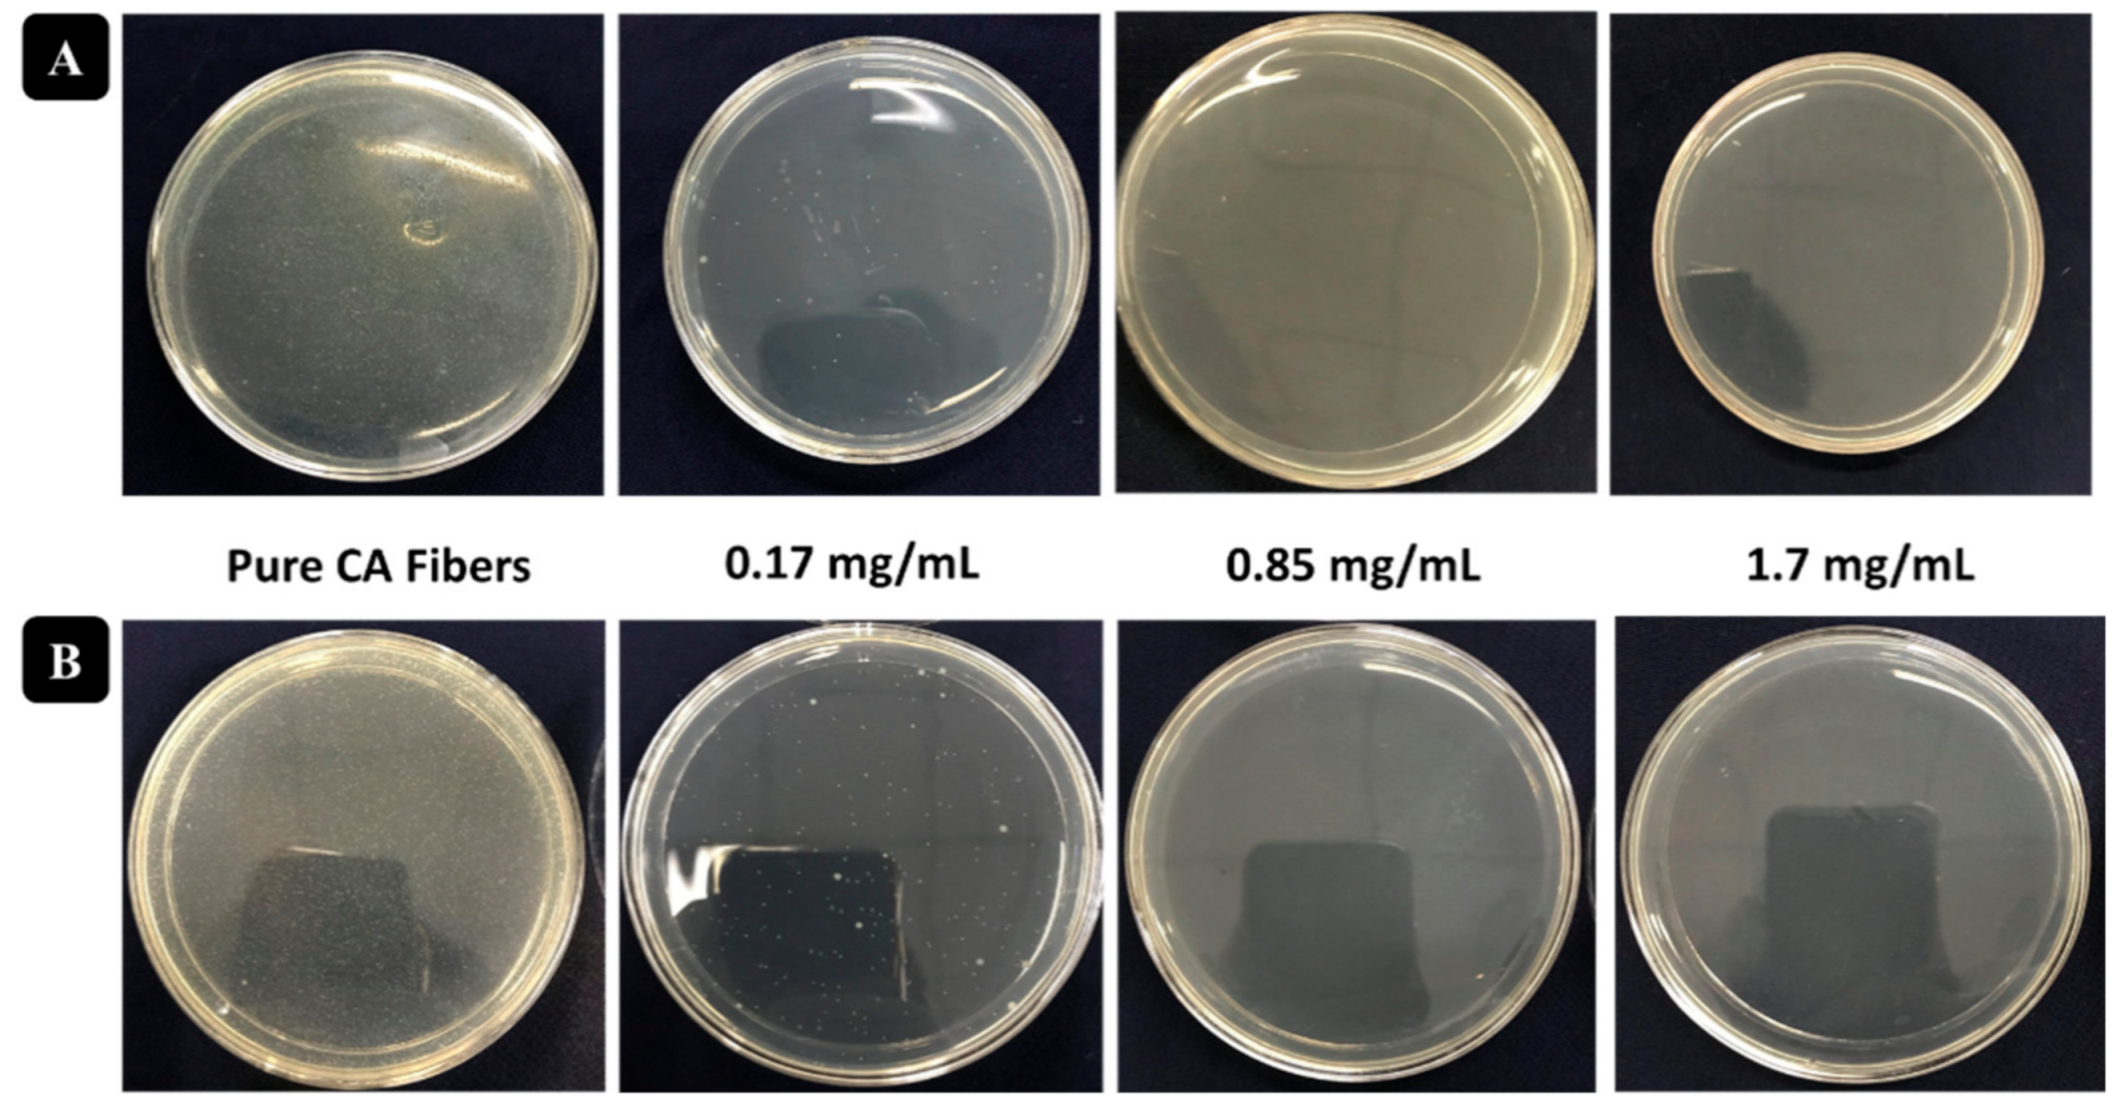
Polymers 13 01411 g007

Green Synthesis and Incorporation of Sericin Silver Nanoclusters into Electrospun Ultrafine Cellulose Acetate Fibers for Anti-Bacterial Applications
Abstract
1. Introduction
2. Experimental
2.1. Materials
2.2. Synthesis of Sericin-AuNCs
2.3. Electrospinning
2.4. Antibacterial Activity
2.5. Material Analysis
3. Results and Discussion
3.1. Synthesis of Sericin-AgNCs
3.2. Physico-Chemical Analysis
3.3. Antibacterial Activity Assessment
4. Conclusions
Author Contributions
Funding
Institutional Review Board Statement
Informed Consent Statement
Data Availability Statement
Acknowledgments
Conflicts of Interest
References
- Naeimi, A.; Payandeh, M.; Ghara, A.R.; Ghadi, F.E. In vivo evaluation of the wound healing properties of bio-nanofiber chitosan/polyvinyl alcohol incorporating honey and Nepeta dschuparensis. Carbohydr. Polym. 2020, 240, 116315. [Google Scholar] [CrossRef] [PubMed]
- Shefa, A.A.; Sultana, T.; Park, M.K.; Lee, S.Y.; Gwon, J.-G.; Lee, B.-T. Curcumin incorporation into an oxidized cellulose nanofiber-polyvinyl alcohol hydrogel system promotes wound healing. Mater. Des. 2020, 186, 108313. [Google Scholar] [CrossRef]
- Saratale, R.G.; Ghodake, G.S.; Shinde, S.K.; Cho, S.-K.; Saratale, G.D.; Pugazhendhi, A.; Bharagava, R.N. Photocatalytic activity of CuO/Cu(OH)2 nanostructures in the degradation of Reactive Green 19A and textile effluent, phytotoxicity studies and their biogenic properties (antibacterial and anticancer). J. Environ. Manag. 2018, 223, 1086–1097. [Google Scholar] [CrossRef] [PubMed]
- Saratale, R.G.; Shin, H.-S.; Kumar, G.; Benelli, G.; Ghodake, G.S.; Jiang, Y.Y.; Kim, D.S.; Saratale, G.D. Exploiting fruit byproducts for eco-friendly nanosynthesis: Citrus × clementina peel extract mediated fabrication of silver nanoparticles with high efficacy against microbial pathogens and rat glial tumor C6 cells. Environ. Sci. Pollut. Res. 2017, 25, 10250–10263. [Google Scholar] [CrossRef]
- Matsumura, Y.; Yoshikata, K.; Kunisaki, S.-I.; Tsuchido, T. Mode of Bactericidal Action of Silver Zeolite and Its Comparison with That of Silver Nitrate. Appl. Environ. Microbiol. 2003, 69, 4278–4281. [Google Scholar] [CrossRef]
- Saratale, R.G.; Saratale, G.D.; Ghodake, G.; Cho, S.-K.; Kadam, A.; Kumar, G.; Jeon, B.-H.; Pant, D.; Bhatnagar, A.; Shin, H.S. Wheat straw extracted lignin in silver nanoparticles synthesis: Expanding its prophecy towards antineoplastic potency and hydrogen peroxide sensing ability. Int. J. Biol. Macromol. 2019, 128, 391–400. [Google Scholar] [CrossRef]
- Abduraimova, A.; Molkenova, A.; Duisembekova, A.; Mulikova, T.; Kanayeva, D.; Atabaev, T. Cetyltrimethylammonium Bromide (CTAB)-Loaded SiO2–Ag Mesoporous Nanocomposite as an Efficient Antibacterial Agent. Nanomaterials 2021, 11, 477. [Google Scholar] [CrossRef]
- Sheikh, F.A.; Barakat, N.A.M.; Kanjwal, M.A.; Chaudhari, A.A.; Jung, I.-H.; Lee, J.H.; Kim, H.Y. Electrospun antimicrobial polyurethane nanofibers containing silver nanoparticles for biotechnological applications. Macromol. Res. 2009, 17, 688–696. [Google Scholar] [CrossRef]
- Saratale, G.D.; Saratale, R.G.; Kim, D.-S.; Kim, D.-Y.; Shin, H.S. Exploiting Fruit Waste Grape Pomace for Silver Nanoparticles Synthesis, Assessing Their Antioxidant, Antidiabetic Potential and Antibacterial Activity Against Human Pathogens: A Novel Approach. Nanomaterials 2020, 10, 1457. [Google Scholar] [CrossRef]
- Chae, H.H.; Kim, B.-H.; Yang, K.S.; Rhee, J.I. Synthesis and antibacterial performance of size-tunable silver nanoparticles with electrospun nanofiber composites. Synth. Met. 2011, 161, 2124–2128. [Google Scholar] [CrossRef]
- Panáček, A.; Kvítek, L.; Prucek, R.; Kolář, M.; Večeřová, R.; Pizúrová, N.; Sharma, V.K.; Nevěčná, T.; Zbořil, R. Silver Colloid Nanoparticles: Synthesis, Characterization, and Their Antibacterial Activity. J. Phys. Chem. B 2006, 110, 16248–16253. [Google Scholar] [CrossRef]
- Pal, S.; Tak, Y.K.; Song, J.M. Does the Antibacterial Activity of Silver Nanoparticles Depend on the Shape of the Nanoparticle? A Study of the Gram-Negative Bacterium Escherichia coli. Appl. Environ. Microbiol. 2007, 73, 1712–1720. [Google Scholar] [CrossRef]
- Yang, X.; Gondikas, A.P.; Marinakos, S.M.; Auffan, M.; Liu, J.; Hsu-Kim, H.; Meyer, J.N. Mechanism of Silver Nanoparticle Toxicity Is Dependent on Dissolved Silver and Surface Coating inCaenorhabditis elegans. Environ. Sci. Technol. 2011, 46, 1119–1127. [Google Scholar] [CrossRef]
- El Badawy, A.M.; Silva, R.G.; Morris, B.; Scheckel, K.G.; Suidan, M.T.; Tolaymat, T.M. Surface Charge-Dependent Toxicity of Silver Nanoparticles. Environ. Sci. Technol. 2011, 45, 283–287. [Google Scholar] [CrossRef]
- Gao, P.; Chang, X.; Zhang, D.; Cai, Y.; Chen, G.; Wang, H.; Wang, T.; Kong, T. Synergistic integration of metal nanoclusters and biomolecules as hybrid systems for therapeutic applications. Acta Pharm. Sin. B 2020. [Google Scholar] [CrossRef]
- Wang, B.; Zhao, M.; Mehdi, M.; Wang, G.; Gao, P.; Zhang, K.-Q. Biomolecule-assisted synthesis and functionality of metal nanoclusters for biological sensing: A review. Mater. Chem. Front. 2019, 3, 1722–1735. [Google Scholar] [CrossRef]
- Luo, Z.; Zheng, K.; Xie, J. Engineering ultrasmall water-soluble gold and silver nanoclusters for biomedical applications. Chem. Commun. 2014, 50, 5143–5155. [Google Scholar] [CrossRef]
- Choi, H.; Ko, S.-J.; Choi, Y.; Joo, P.; Kim, T.; Lee, B.R.; Jung, J.-W.; Choi, H.J.; Cha, M.; Jeong, J.-R.; et al. Versatile surface plasmon resonance of carbon-dot-supported silver nanoparticles in polymer optoelectronic devices. Nat. Photon 2013, 7, 732–738. [Google Scholar] [CrossRef]
- Jin, J.-C.; Wu, X.-J.; Xu, J.; Wang, B.-B.; Jiang, F.-L.; Liu, Y. Ultrasmall silver nanoclusters: Highly efficient antibacterial activity and their mechanisms. Biomater. Sci. 2016, 5, 247–257. [Google Scholar] [CrossRef]
- Saratale, R.G.; Cho, S.-K.; Saratale, G.D.; Kadam, A.A.; Ghodake, G.S.; Kumar, M.; Bharagava, R.N.; Kumar, G.; Kim, D.S.; Mulla, S.I.; et al. A comprehensive overview and recent advances on polyhydroxyalkanoates (PHA) production using various organic waste streams. Bioresour. Technol. 2021, 325, 124685. [Google Scholar] [CrossRef]
- Chao, S.; Li, Y.; Zhao, R.; Zhang, L.; Li, Y.; Wang, C.; Li, X. Synthesis and characterization of tigecycline-loaded sericin/poly (vinyl alcohol) composite fibers via electrospinning as antibacterial wound dressings. J. Drug Deliv. Sci. Technol. 2018, 44, 440–447. [Google Scholar] [CrossRef]
- Zhao, R.; Li, X.; Sun, B.; Zhang, Y.; Zhang, D.; Tang, Z.; Chen, X.; Wang, C. Electrospun chitosan/sericin composite nanofibers with antibacterial property as potential wound dressings. Int. J. Biol. Macromol. 2014, 68, 92–97. [Google Scholar] [CrossRef]
- Khan, M.Q.; Kharaghani, D.; Shahzad, A.; Duy, N.P.; Hasegawa, Y.; Lee, J.; Kim, I.S. Fabrication of Antibacterial Nanofibers Composites by Functionalizing the Surface of Cellulose Acetate Nanofibers. ChemistrySelect 2020, 5, 1315–1321. [Google Scholar] [CrossRef]
- Mahar, F.K.; He, L.; Wei, K.; Mehdi, M.; Zhu, M.; Gu, J.; Zhang, K.; Khatri, Z.; Kim, I. Rapid adsorption of lead ions using porous carbon nanofibers. Chemosphere 2019, 225, 360–367. [Google Scholar] [CrossRef]
- Mehdi, M.; Mahar, F.K.; Qureshi, U.A.; Khatri, M.; Khatri, Z.; Ahmed, F.; Kim, I.S. Preparation of colored recycled polyethylene terephthalate nanofibers from waste bottles: Physicochemical studies. Adv. Polym. Technol. 2018, 37, 2820–2827. [Google Scholar] [CrossRef]
- Son, W.K.; Youk, J.H.; Park, W.H. Antimicrobial cellulose acetate nanofibers containing silver nanoparticles. Carbohydr. Polym. 2006, 65, 430–434. [Google Scholar] [CrossRef]
- Khatri, M.; Ahmed, F.; Ali, S.; Mehdi, M.; Ullah, S.; Duy-Nam, P.; Khatri, Z.; Kim, I.S. Photosensitive nanofibers for data recording and erasing. J. Text. Inst. 2021, 112, 429–436. [Google Scholar] [CrossRef]
- Saquing, C.D.; Manasco, J.L.; Khan, S.A. Electrospun Nanoparticle-Nanofiber Composites via a One-Step Synthesis. Small 2009, 5, 944–951. [Google Scholar] [CrossRef]
- Yang, Y.; Zhang, Z.; Wan, M.; Wang, Z.; Zou, X.; Zhao, Y.; Sun, L. A Facile Method for the Fabrication of Silver Nanoparticles Surface Decorated Polyvinyl Alcohol Electrospun Nanofibers and Controllable Antibacterial Activities. Polymers 2020, 12, 2486. [Google Scholar] [CrossRef]
- Khalil, K.A.; Fouad, H.; Elsarnagawy, T.; Almajhdi, F.N. Preparation and characterization of electrospun PLGA/silver composite nanofibers for biomedical applications. Int. J. Electrochem. Sci. 2013, 8, 3483–3493. [Google Scholar]
- Khatri, M.; Ahmed, F.; Shaikh, I.; Phan, D.-N.; Khan, Q.; Khatri, Z.; Lee, H.; Kim, I.S. Dyeing and characterization of regenerated cellulose nanofibers with vat dyes. Carbohydr. Polym. 2017, 174, 443–449. [Google Scholar] [CrossRef] [PubMed]
- Kim, C.H.; Kim, S.Y.; Choi, K.S. Synthesis and Antibacterial Activity of Water-soluble Chitin Derivatives. Polym. Adv. Technol. 1997, 8, 319–325. [Google Scholar] [CrossRef]
- Liang, S.; Zhang, G.; Min, J.; Ding, J.; Jiang, X. Synthesis and Antibacterial Testing of Silver/Poly (Ether Amide) Composite Nanofibers with Ultralow Silver Content. J. Nanomater. 2014, 2014, 1–10. [Google Scholar] [CrossRef]
- Hussain, N.; Mehdi, M.; Yousif, M.; Ali, A.; Ullah, S.; Siyal, S.H.; Hussain, T.; Kim, I. Synthesis of Highly Conductive Electrospun Recycled Polyethylene Terephthalate Nanofibers Using the Electroless Deposition Method. Nanomaterials 2021, 11, 531. [Google Scholar] [CrossRef]
- Jiang, G.-H.; Wang, L.; Chen, T.; Yu, H.-J.; Wang, J.-J. Preparation and characterization of dendritic silver nanoparticles. J. Mater. Sci. 2005, 40, 1681–1683. [Google Scholar] [CrossRef]
- Xu, F.; Weng, B.; Materon, L.A.; Kuang, A.; Trujillo, J.A.; Lozano, K. Fabrication of cellulose fine fiber based membranes embedded with silver nanoparticles via Forcespinning. J. Polym. Eng. 2016, 36, 269–278. [Google Scholar] [CrossRef]
- Ahmed, F.; Arbab, A.A.; Jatoi, A.W.; Khatri, M.; Memon, N.; Khatri, Z.; Kim, I.S. Ultrasonic-assisted deacetylation of cellulose acetate nanofibers: A rapid method to produce cellulose nanofibers. Ultrason. Sonochem. 2017, 36, 319–325. [Google Scholar] [CrossRef]
- Hadipour-Goudarzi, E.; Montazer, M.; Latifi, M.; Aghaji, A.A.G. Electrospinning of chitosan/sericin/PVA nanofibers incorporated with in situ synthesis of nano silver. Carbohydr. Polym. 2014, 113, 231–239. [Google Scholar] [CrossRef]
- Islam, M.S.; Yeum, J.H.J.C.; Physicochemical, S.A.; Aspects, E. Electrospun pullulan/poly (vinyl alcohol)/silver hybrid nanofibers: Preparation and property characterization for antibacterial activity. Colloids Surf. A Physicochem. Eng. Asp. 2013, 436, 279–286. [Google Scholar] [CrossRef]

Publisher’s Note: MDPI stays neutral with regard to jurisdictional claims in published maps and institutional affiliations. |
© 2021 by the authors. Licensee MDPI, Basel, Switzerland. This article is an open access article distributed under the terms and conditions of the Creative Commons Attribution (CC BY) license (https://creativecommons.org/licenses/by/4.0/).
Share and Cite
Mehdi, M.; Qiu, H.; Dai, B.; Qureshi, R.F.; Hussain, S.; Yousif, M.; Gao, P.; Khatri, Z. Green Synthesis and Incorporation of Sericin Silver Nanoclusters into Electrospun Ultrafine Cellulose Acetate Fibers for Anti-Bacterial Applications. Polymers 2021, 13, 1411. https://doi.org/10.3390/polym13091411
Mehdi M, Qiu H, Dai B, Qureshi RF, Hussain S, Yousif M, Gao P, Khatri Z. Green Synthesis and Incorporation of Sericin Silver Nanoclusters into Electrospun Ultrafine Cellulose Acetate Fibers for Anti-Bacterial Applications. Polymers. 2021; 13(9):1411. https://doi.org/10.3390/polym13091411
Chicago/Turabian StyleMehdi, Mujahid, Huihui Qiu, Bing Dai, Raja Fahad Qureshi, Sadam Hussain, Muhammad Yousif, Peng Gao, and Zeeshan Khatri. 2021. "Green Synthesis and Incorporation of Sericin Silver Nanoclusters into Electrospun Ultrafine Cellulose Acetate Fibers for Anti-Bacterial Applications" Polymers 13, no. 9: 1411. https://doi.org/10.3390/polym13091411
APA StyleMehdi, M., Qiu, H., Dai, B., Qureshi, R. F., Hussain, S., Yousif, M., Gao, P., & Khatri, Z. (2021). Green Synthesis and Incorporation of Sericin Silver Nanoclusters into Electrospun Ultrafine Cellulose Acetate Fibers for Anti-Bacterial Applications. Polymers, 13(9), 1411. https://doi.org/10.3390/polym13091411

